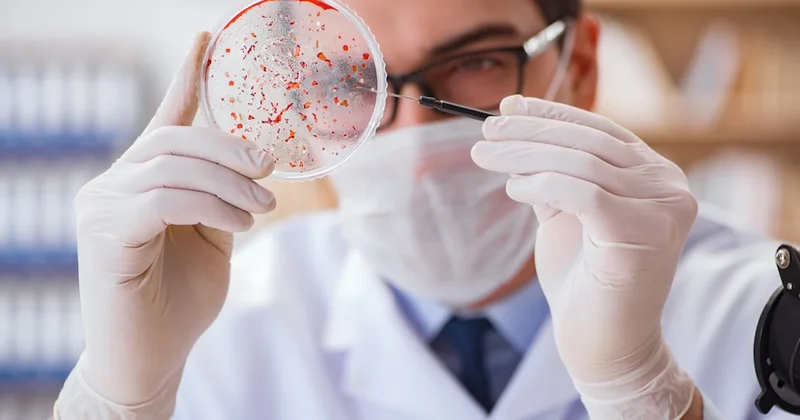
Tam 5 bin yıldır buz altındaydı... Doktorlar şaşırdı, modernlerine bile dirençli Sözcü Gazetesi

Anlaşma açıklaması geldi altın çakıldı! Sözcü Gazetesi
Sozcu sayfasından elde edilen bilgilere dayanarak, Ankara24.com duyuru yapıyor.
Altının onsu, İran’ın ABD ile yürütülen nükleer müzakerelerde “anlaşmaya varıldığını” açıklamasının ardından geriledi.
ABD ile İran arasında yürütülen dolaylı müzakerelerin ikinci turu Cenevre’de sona erdi. Tarafların heyetleri görüşmelerin ardından toplantı yerinden ayrıldı. Ancak İran tarafı, anlaşmaya varmak ve Washington’un olası bir askeri müdahalesini önlemek amacıyla gerekirse İsviçre’de günlerce hatta haftalarca kalmaya hazır olduğunu belirtti.
Görüşmelerin tamamlanmasından yaklaşık bir saat sonra servis edilen başlığın ardından petrol ve altın fiyatlarında sert düşüş görüldü.
Ons altın görüşme öncesinde 4 bin 918 dolarda bulunuyordu. Görüşmelerin ardından 4 bin 842 dolara kadar gerileyerek şu anda 4 bin 897 dolarda hareketleniyor.
Gümüş fiyatları da düşüş gösterdi. ABD - İran görüşmesi öncesinde 74,91 dolarda bulunuyordu. Görüşmelerin ardından 72,70 dolara geriledi.
Bu konudaki diğer haberler:
Görüntülenme:49
Bu haber kaynaktan arşivlenmiştir 17 Şubat 2026 17:12 kaynağından arşivlendi



Giriş yap
Haberler
Türkiye'de Hava durumu
Türkiye'de Manyetik fırtınalar
Türkiye'de Namaz vakti
Türkiye'de Değerli metaller
Türkiye'de Döviz çevirici
Türkiye'de Kredi hesaplayıcı
Türkiye'de Kripto para
Türkiye'de Burçlar
Türkiye'de Soru - Cevap
İnternet hızını test et
Türkiye Radyosu
Türkiye televizyonu
Hakkımızda








En çok okunanlar